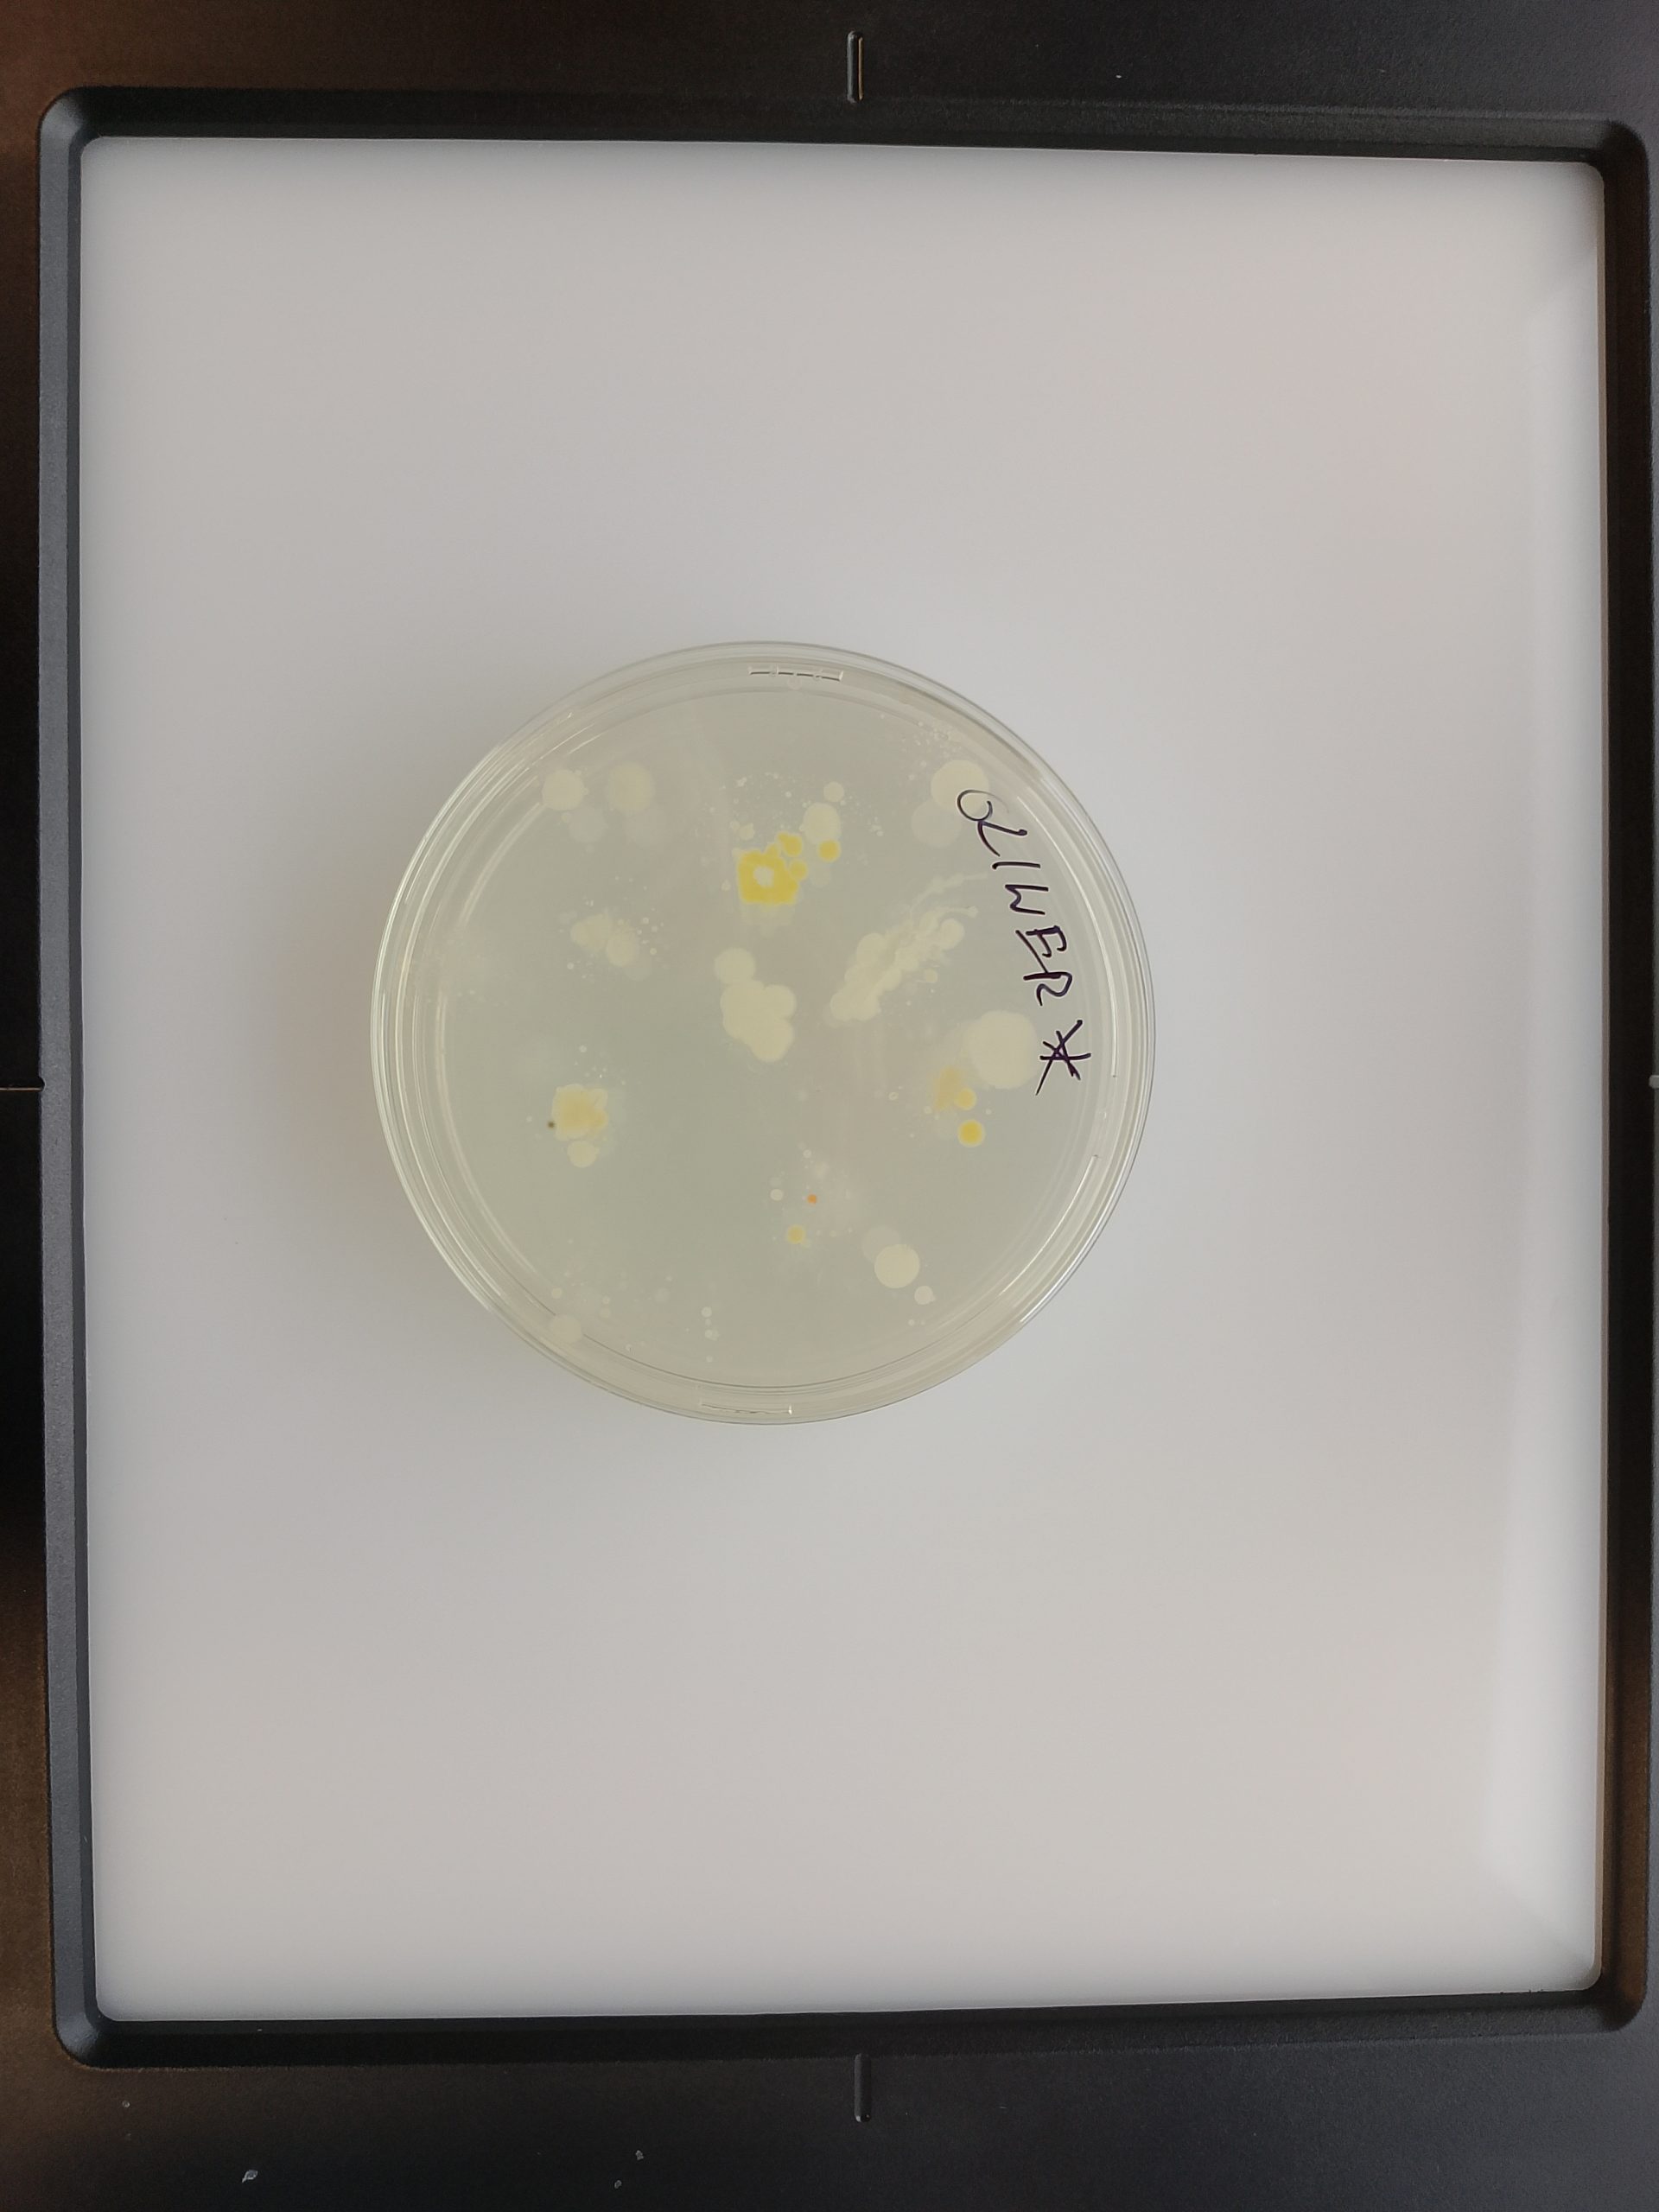

Galeria
Zapraszamy do obejrzenia fotorelacji z ceremonii wręczenia dyplomów studentom studiów anglojęzycznych – biotechnology i medical biotechnology.Gratulujemy wszystkim naszym wspaniałym Absolwentom i życzymy sukcesów i spełnienia w życiu zawodowym. (fot. Paweł Piotrowski / UWr)